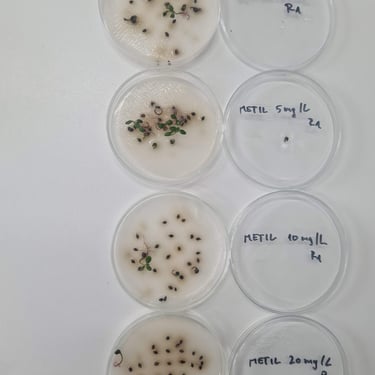

The effect of isothiocyanates on Ambrosia artemisiifolia L.

The effect of phenolic acids on carotenoids and antioxidative enzymes












The effect of phenolic acids on beneficial soil microorganisms


Contact:
mscepanovic@agr.hr
+38512394033
© 2024. All rights reserved.
